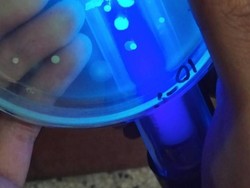
Mahasiswa Unibraw Temukan Bahan Alternatif Tinta Bolpoin dari Bakteri

detikNews
Mahasiswa Unibraw Temukan Bahan Alternatif Tinta Bolpoin dari Bakteri
Tiga mahasiswa Jurusan Fisika, Fakultas Matematika dan Ilmu Pengetahuan Alam Universitas Brawijaya menemukan alternatif bahan baku tinta bolpoin dari alam.
Kamis, 02 Agu 2018 12:05 WIB